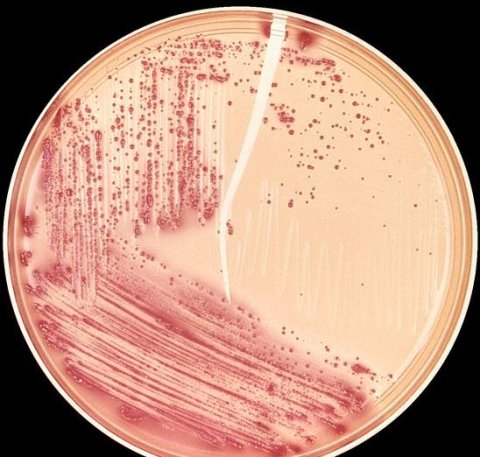

Bakteria, o której wiele się ostatnio słyszy, może powodować różne infekcje. Najczęstszymi z nich są: zapalenie zatok, pęcherza moczowego i opon mózgowych. E.coli jest odporna na działanie prawie każdego antybiotyku, a jej obecność w organizmie może okazać się śmiertelnie niebezpieczna.
Nazwa bakterii pochodzi od nazwiska jej odkrywcy - austriackiego pediatry i bakteriologa Theodora Eschericha. Bytując w jelicie grubym człowieka i zwierząt endotermicznych, okazuje się być ona pożytecznym składnikiem flory bakteryjnej, ze względu na to, że pomaga w procesie rozkładu pokarmu oraz w produkcji witamin z grupy B i K.
Bakteria staje się niebezpieczna dopiero w momencie opuszczenia wraz z kałem układu pokarmowego. Wtedy może doprowadzić do wystąpienia różnych infekcji, np.:
- dróg moczowych - szczególnie u kobiet i dziewczynek, infekcje powstają w związku z przenoszeniem bakterii z odbytu do cewki moczowej, za sprawą nieprawidłowego podcierania lub, w przypadku dzieci, zbyt powolnej zmiany pieluch. W taki oto sposób E.coli może wywoływać zapalenie pęchęrza i nerek,a w przypadku częstych nawrotów może doprowadzić do niewydolności nerek,
- przewlekłe zapalenie zatok - bakteria doprowadza do tworzenia społeczności wielokomórkowych, złożonych z drobnoustrojów, które często są oporne na leczenie i czasami trzeba je usuwać operacyjnie, mechanicznie wypłukując,
- zapalenie opon mózgowych - jest jedną z dwóch bakterii najczęściej wywołujących zapalenie opon mózgowych u noworodków, jest również najczęstszą przyczyną sepsy.
Źródło: zdrowie.gazeta.pl / własne